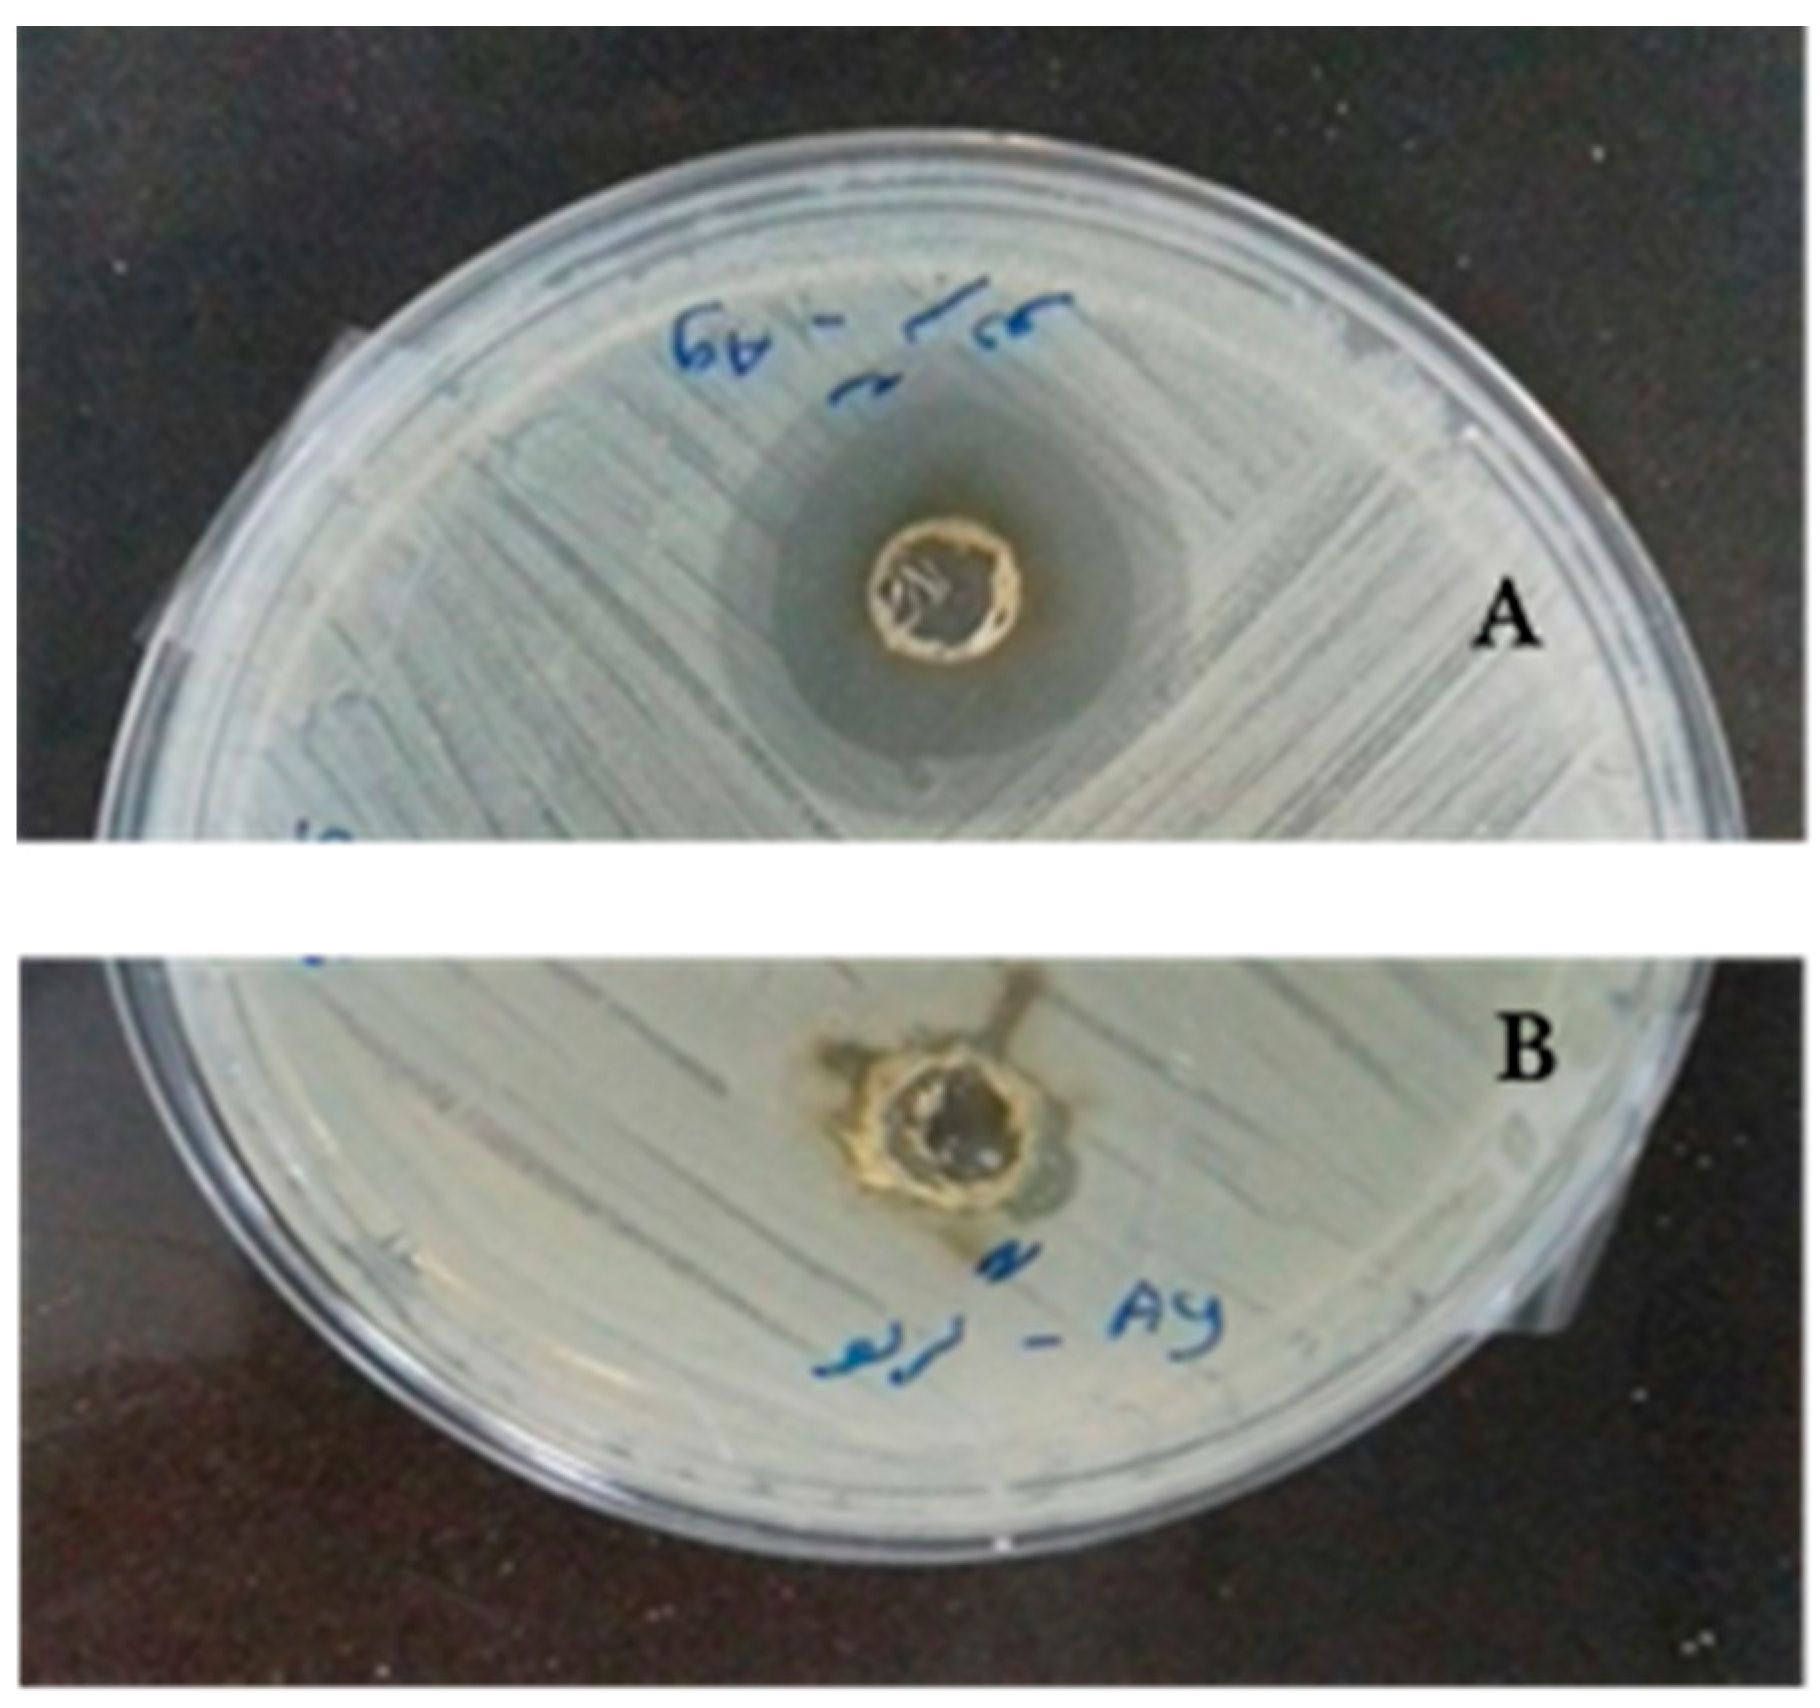
Antibiotics 07 00068 g007

Microwave-Assisted Green Synthesis of Silver Nanoparticles Using Juglans regia Leaf Extract and Evaluation of Their Physico-Chemical and Antibacterial Properties
Abstract
:1. Introduction
2. Results
2.1. Formation of Ag NPs
2.2. Models Generation and Synthesis Conditions Optimization
2.3. Physico-Chemical Characteristics of the Synthesized Ag NPs at Obtained Optimum Conditions
2.4. Antibacterial Activity
3. Materials and Methods
3.1. Materials
3.2. Preparation of J. regia Leaf Extract
3.3. Ag NPs Synthesis Using J. regia Leaf Extract
3.4. Physico-Chemical Assay
3.4.1. Fourier Transform-Infrared (FT-IR) Spectra Analysis
3.4.2. Surface Plasmon Resonance
3.4.3. Particle Size, Particle Size Distribution, Polydispersity Index and Zeta Potential of the Synthesized Ag NPs
3.5. Antibacterial Assay
3.6. Experimental Design, Statistical Analysis and Optimization Procedure
4. Conclusions
Author Contributions
Funding
Acknowledgments
Conflicts of Interest
References
- Mohammadlu, M.; Jafarizadeh-Malmiri, H.; Maghsoudi, H. A review on green silver nanoparticles based on plants: Synthesis, potential applications and eco-friendly approach. Int. Food Res. J. 2016, 23, 446–463. [Google Scholar]
- Kon, K.; Rai, M. Metallic nanoparticles: Mechanism of antibacterial action and influencing factors. J. Comp. Clin. Pathol. Res. 2013, 2, 160–174. [Google Scholar]
- Zhou, Y.; Kong, Y.; Kundu, S.; Cirillo, J.D.; Liang, H. Antibacterial activities of gold and silver nanoparticles against Escherichia coli and Bacillus calmette-Guérin. J. Nanobiotechnol. 2012, 10, 19–28. [Google Scholar] [CrossRef] [PubMed]
- Ingale, A.G.; Chaudhari, A. Biogenic synthesis of nanoparticles and potential applications: An eco-friendly approach. J. Nanomed. Nanotechnol. 2013, 4, 165–167. [Google Scholar] [CrossRef]
- Hebbalalu, D.; Lalley, J.; Nadagouda, M.N.; Varma, R.S. Greener techniques for the synthesis of silver nanoparticles using plant extracts, enzymes, bacteria, biodegradable polymers, and microwaves. ACS Sustain. Chem. Eng. 2013, 1, 703–712. [Google Scholar] [CrossRef]
- Vamanu, E.; Ene, M.; Bita, B.; Ionescu, C.; Craciun, L.; Sarbu, I. In vitro human microbiota response to exposure to silver nanoparticles biosynthesized with mushroom extract. Nutrients 2018, 10, 607. [Google Scholar] [CrossRef] [PubMed]
- Zhang, Y.; Cheng, X.; Zhang, Y.; Xue, X.; Fu, Y. Biosynthesis of silver nanoparticles at room temperature using aqueous Aloe leaf extract and antibacterial properties. Colloids Surf. A Physicochem. Eng. Asp. 2013, 423, 63–68. [Google Scholar] [CrossRef]
- Mohammadlu, M.; Jafarizadeh-Malmiri, H.; Maghsoudi, H. Hydrothermal green silver nanoparticles synthesis using Pelargonium/Geranium leaf extract and evaluation of their antifungal activity. Green Process. Synth. 2017, 6, 31–42. [Google Scholar] [CrossRef]
- Ahmadi, O.; Jafarizadeh-Malmiri, H.; Jodeiri, N. Eco-friendly microwave enhanced green silver nanoparticles synthesis using Aloe vera leaf extract and their physico-chemical and antibacterial studies. Green Process. Synth. 2018, 7, 231–240. [Google Scholar] [CrossRef]
- Torabfam, M.; Jafarizadeh-Malmiri, H. Microwave–enhanced silver nanoparticles synthesis using chitosan biopolymer–Optimization of the process conditions and evaluation of their characteristics. Green Process. Synth. 2017. [Google Scholar] [CrossRef]
- Jaiswal, B.S.; Tailang, M. Juglans regia: A review of its traditional uses phytochemistry and pharmacology. Indo Am. J. Pharm. Res. 2017, 7, 390–398. [Google Scholar]
- Amaral, J.S.; Seabra, R.M.; Andrade, P.B. Phenolic profile in the quality control of walnut (Juglans regia L.) leaf. Food Chem. 2004, 88, 373–379. [Google Scholar] [CrossRef]
- Pereira, J.A.; Oliveira, I.; Sousa, A. Walnut (Juglans regia L.) leaf: Phenolic compounds, antimicrobial activity and antioxidant potential of different cultivars. Food Chem. Toxicol. 2007, 45, 2287–2295. [Google Scholar] [CrossRef] [PubMed]
- Eskandari-Nojedehi, M.; Jafarizadeh-Malmiri, H.; Rahbar-Shahrouzi, J. Optimization of processing parameters in green synthesis of gold nanoparticles using microwave and edible mushroom (Agaricus bisporus) extract and evaluation of their antibacterial activity. Nanotechnol. Rev. 2016, 5, 537–548. [Google Scholar] [CrossRef]
- Eskandari-Nojedehi, M.; Jafarizadeh-Malmiri, H.; Jafarizad, A. Microwave accelerated green synthesis of gold nanoparticles using gum Arabic and their physico-chemical properties assessments. Z. Phys. Chem. 2018, 232, 325–343. [Google Scholar] [CrossRef]
- Amirkhani, L.; Moghaddas, J.; Jafarizadeh-Malmiri, H. Candida rugosa lipase immobilization on magnetic silica aerogel nanodispersion. RSC Adv. 2016, 6, 12676–12687. [Google Scholar] [CrossRef]
- Anarjan, N.; Jaberi, N.; Yeganeh-Zare, S.; Banafshehchin, E.; Rahimirad, A.; Jafarizadeh-Malmiri, H. Optimization of mixing parameters for α-tocopherol nanodispersions prepared using solvent displacement method. J. Am. Oil Chem. Soc. 2014, 91, 1397–1405. [Google Scholar] [CrossRef]
- Eskandari-Nojedehi, M.; Jafarizadeh-Malmiri, H.; Rahbar-Shahrouzi, J. Hydrothermal biosynthesis of gold nanoparticle using mushroom (Agaricus bisporous) extract: Physico-chemical characteristics and antifungal activity studies. Green Process. Synth. 2018, 7, 38–47. [Google Scholar] [CrossRef]
- Anarjan, N.; Jafarizadeh-Malmiri, H.; Nehdi, I.A.; Sbihi, H.M.; Al-Resayes, S.I.; Tan, C.P. Effects of homogenization process parameters on physicochemical properties of astaxanthin nanodispersions prepared using a solvent-diffusion technique. Int. J. Nanomed. 2015, 10, 1109–1118. [Google Scholar]
- Ahdno, H.; Jafarizadeh-Malmiri, H. Development of a sequenced enzymatically pre-treatment and filter pre-coating process to clarify date syrup. Food Bioprod. Process. 2017, 101, 193–204. [Google Scholar] [CrossRef]

| Sample No. | Amount of Leaf Extract (mL) | Amount of Silver Salt (mL) | λmax (nm) | Concentration (ppm) | ||
|---|---|---|---|---|---|---|
| Exp | Pre | Exp | Pre | |||
| 1 | 0.10 | 20.00 | 425 | 424.896 | 104.813 | 101.702 |
| 2 | 0.78 | 16.46 | 429 | 429.104 | 100.003 | 97.802 |
| 3 | 0.78 | 23.53 | 424 | 424.00 | 93.503 | 96.614 |
| 4 | 0.50 | 15.00 | 427 | 426.854 | 72.443 | 74.643 |
| 5 | 0.50 | 25.00 | * | * | 48.393 | 43.081 |
| 6 | 0.50 | 20.00 | 426 | 427.250 | 56.453 | 61.835 |
| 7 | 0.50 | 20.00 | 426 | 427.250 | 56.453 | 61.835 |
| 8 | 0.217 | 23.53 | 426 | 426.043 | 50.343 | 55.654 |
| 9 | 0.50 | 20.00 | 428 | 427.250 | 66.073 | 61.835 |
| 10 | 0.90 | 20.00 | 427 | 426.957 | * | * |
| 11 | 0.217 | 16.46 | 424 | 424.146 | * | * |
| 12 | 0.50 | 20.00 | 429 | 427.250 | 66.723 | 61.835 |
| 13 | 0.50 | 20.00 | * | * | 63.473 | 61.835 |
| Regression Coefficient | λmax (nm) | Concentration (ppm) |
|---|---|---|
| β0 (constant) | 386.44 | 249.7 |
| β1 (main effect) | −45,084 | −513.04 |
| β2 (main effect) | 3.09 | −3.68 |
| β11 (quadratic effect) | −8.27 | 336.8 |
| β22 (quadratic effect) | −0.061 | −0.119 |
| β12 (interaction effect) | −1.75 | 10.56 |
| R2 | 77.81% | 95.25% |
| R2-adj | 85.62% | 90.49% |
| Lack of fit (p-value) | 0.985 | 0.142 |
| Main Effects | Main Effects | Quadratic Effects | Interacted Effect | ||
|---|---|---|---|---|---|
| X1 | X2 | X11 | X22 | X1 X2 | |
| λmax (nm) (p-value) | 0.003 | 0.693 | 0.00 | 0.580 | 0.045 |
| Concentration (ppm) (p-value) | 0.018 | 0.153 | 0.224 | 0.247 | 0.030 |
© 2018 by the authors. Licensee MDPI, Basel, Switzerland. This article is an open access article distributed under the terms and conditions of the Creative Commons Attribution (CC BY) license (http://creativecommons.org/licenses/by/4.0/).
Share and Cite
Eshghi, M.; Vaghari, H.; Najian, Y.; Najian, M.J.; Jafarizadeh-Malmiri, H.; Berenjian, A. Microwave-Assisted Green Synthesis of Silver Nanoparticles Using Juglans regia Leaf Extract and Evaluation of Their Physico-Chemical and Antibacterial Properties. Antibiotics 2018, 7, 68. https://doi.org/10.3390/antibiotics7030068
Eshghi M, Vaghari H, Najian Y, Najian MJ, Jafarizadeh-Malmiri H, Berenjian A. Microwave-Assisted Green Synthesis of Silver Nanoparticles Using Juglans regia Leaf Extract and Evaluation of Their Physico-Chemical and Antibacterial Properties. Antibiotics. 2018; 7(3):68. https://doi.org/10.3390/antibiotics7030068
Chicago/Turabian StyleEshghi, Mahsa, Hamideh Vaghari, Yahya Najian, Mohammad Javad Najian, Hoda Jafarizadeh-Malmiri, and Aydin Berenjian. 2018. "Microwave-Assisted Green Synthesis of Silver Nanoparticles Using Juglans regia Leaf Extract and Evaluation of Their Physico-Chemical and Antibacterial Properties" Antibiotics 7, no. 3: 68. https://doi.org/10.3390/antibiotics7030068
APA StyleEshghi, M., Vaghari, H., Najian, Y., Najian, M. J., Jafarizadeh-Malmiri, H., & Berenjian, A. (2018). Microwave-Assisted Green Synthesis of Silver Nanoparticles Using Juglans regia Leaf Extract and Evaluation of Their Physico-Chemical and Antibacterial Properties. Antibiotics, 7(3), 68. https://doi.org/10.3390/antibiotics7030068
